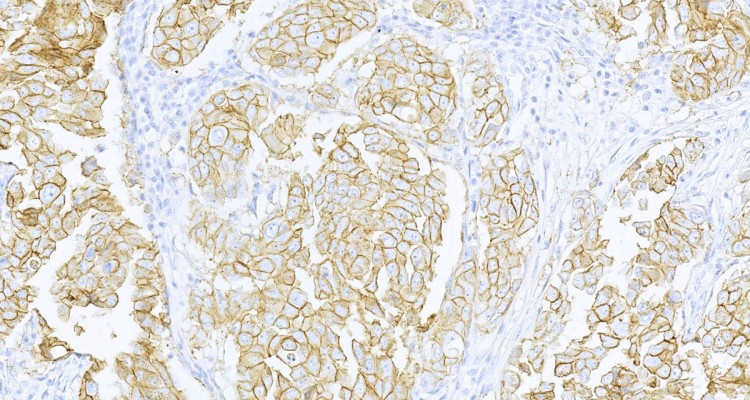

ACP Bièvres – les Ulis réalise des examens d’anatomie et de cytologie pathologiques :
- sur des biopsies et des pièces opératoires de tous les organes,
- sur des prélèvements cytologiques :
- frottis gynécologiques, conventionnels et en phase liquide,
- liquides : urines, épanchements, écoulements, …
- cytoponctions d’organes (thyroïde, sein, ganglion …).
Lorsque cela est nécessaire, les techniques usuelles d’histologie et de cytologie sont complétées par des techniques d’immunohistochimie, d’hybridation in situ et de biologie moléculaire. Dans le cadre de partenariats, les examens de biologie moléculaire sont adressés à des plateformes de biologie moléculaire subventionnées par l’Institut National du Cancer.
Le typage HPV est réalisé sur les frottis gynécologiques, dans le cadre des indications définies par la CNAM (frottis ASC-US) ou à la demande du gynécologue.
ACP Bièvres – les Ulis met à la disposition de ses patients des outils facilitant les échanges et les démarches :
- Le paiement par carte bancaire, en ligne ou par téléphone, permettant le paiement sans se déplacer et économisant les frais postaux qui sont à la charge des patients lorsqu’un règlement par chèque est envoyé par courrier.
- Des informations par SMS pour les patients ayant omis de régler, ou ayant un souci de distribution de courrier, ce qui évite des frais de relance.
- La feuille de soins électronique en ligne afin de faciliter et accélérer la prise en charge par la sécurité sociale.
- Un site internet donnant accès à des informations pratiques :
- La localisation d’ACP Bièvres via Google Maps.
- Les coordonnées téléphoniques.
- Un accès direct possible par mail avec la structure.
- Une foire aux questions pour répondre aux interrogations les plus courantes